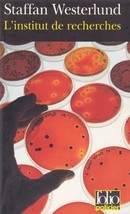
L'Institut de recherches - couverture livre occasion

Scandinave
-
8,00 €
-
3,00 €
-
4,20 €
-
3,50 €
-
3,90 €
-
3,80 €
-
3,80 €
-
3,00 €
-
3,50 €
-
5,50 €
-
7,00 €
-
6,80 €
-
3,00 €
-
4,90 €
-
2,00 €
-
6,00 €
-
3,20 €
-
4,80 €
-
5,50 €
-
5,50 €